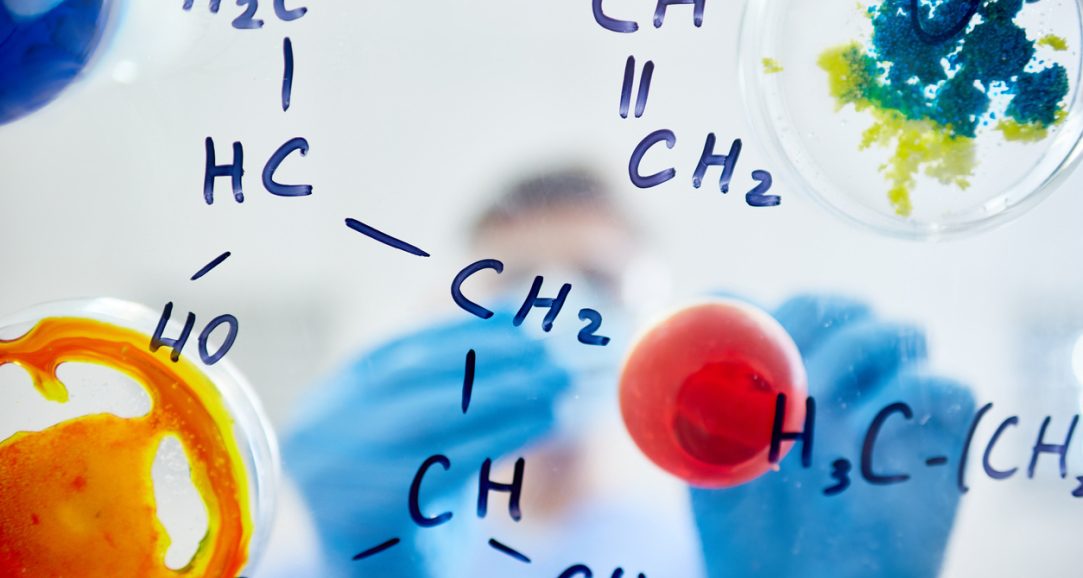

Уже завтра в Україні розпочинається основна сесія зовнішнього незалежного оцінювання. В нашій області працюватиме 64 пункти тестування для школярів. Цьогоріч перший іспит – тестування з хімії, на який у Рівненщині зареєструвалося 400 учасників.
Нагадуємо, що кожному зареєстрованому учаснику надіслано Сертифікат ЗНО-2021. Учням, студентам, які подавали реєстраційні пакети документів у заклади освіти, сертифікати надіслано в заклади освіти. Кожному учаснику необхідно уважно перевірити всі записи – прізвище, ім’я, по батькові, серію та номер документа і дані на інформаційній картці.
За допомогою номера Сертифіката і PIN-кода в ньому, здійснюється доступ до інформаційної сторінки абітурієнта, на якій з 30 квітня 2021 р. розміщені запрошення-перепустки у пункти проведення ЗНО – 2021 року.
Запрошення – перепустку необхідно роздрукувати самостійно, поштою запрошення надіслане не буде.
Необхідно підготувати документи, 2 ручки чорного кольору, захисні маски.
Для уникнення скупчень учасників біля входу до пунктів тестування у запрошенні-перепустці кожного учасника зазначено рекомендований проміжок часу, протягом якого йому варто прибути до пункту тестування і пройти процедуру допуску.
Перед входом до пункту тестування учасникам вимірюватимуть температуру тіла та перевірять наявність ознак респіраторного захворювання.
В умовах пандемії, в Рівненську область надійшла цільова субвенція на придбання засобів захисту, спрямованих на боротьбу з гострою респіраторною хворобою COVID-19, зокрема, антисептиків для рук та поверхонь, халатів, щитків, на що виділено 844 тисячі гривень.
Управлінням освіти і науки Рівненської ОДА було було проведено необхідні закупівлі та доставлено засоби захисту до кожного з 64 пунктів тестування.
Зичимо усім учасникам та причетним до кампанії ЗНО-2021 успіхів.